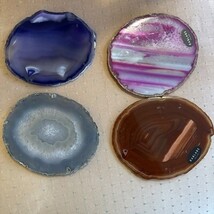
Item image 6

Rablabs Set Of 4 Agate Coasters L 5" X W4” and similar items
RABLABS Set Of 4 Agate Coasters L 5" x W4”
$30.00
(It may be possible to pay only $27.00 instead of $30.00 when you
use your bCredits at checkout)
Sign up and get $5.00 bCredits free to use at checkout and another $5.00 bCredits when you make your first purchase. More info
Share & earn! Sign in, share this or any listing, and you’ll get commission when it sells.
Learn more
View full item details »
Shipping options
Offer policy
OBO - Seller accepts offers on this item.
Details
Return policy
Full refund available for DOAs
Purchase protection
Payment options
PayPal accepted
PayPal Credit accepted
Venmo accepted
PayPal, MasterCard, Visa, Discover, and American Express accepted
Maestro accepted
Amazon Pay accepted
Nuvei accepted
View full item details »
Shipping options
Offer policy
OBO - Seller accepts offers on this item.
Details
Return policy
Full refund available for DOAs
Purchase protection
Payment options
PayPal accepted
PayPal Credit accepted
Venmo accepted
PayPal, MasterCard, Visa, Discover, and American Express accepted
Maestro accepted
Amazon Pay accepted
Nuvei accepted
Item traits
| Category: | |
|---|---|
| Quantity Available: |
Only one in stock, order soon |
| Condition: |
New other (see details) |
| UPC: |
Does not apply |
| Model: |
Coasters |
| Color: |
Brown |
| Item Height: |
Does Not Apply |
| Item Length: |
Does Not Apply |
| Item Width: |
Does Not Apply |
| Brand: |
RabLabs |
| Type: |
coasters |
| Occasion: |
Does Not Apply |
| Style: |
Coasters |
| Material: |
Agate |
| Vintage: |
No |
Listing details
| Seller policies: | |
|---|---|
| Shipping discount: |
Shipping weights of all items added together for savings. |
| Posted for sale: |
February 20 |
| Item number: |
1793684120 |
Item description
The RABLABS Set of 4 Agate Coasters features a stylish and unique design, perfect for adding a touch of elegance to any home decor. Made from natural agate stone, each coaster measures L 5" x W 4" and comes in a set of four, ideal for protecting surfaces and adding a chic touch to your living space. New without box
Loading
This item has been added to your cart
 RABLABS Set Of 4 Agate Coasters L 5" x W4” added to cart.
Only one available in stock
RABLABS Set Of 4 Agate Coasters L 5" x W4” added to cart.
Only one available in stock
View Cart or continue shopping.
 Please wait while we finish adding this item to your cart.
Please wait while we finish adding this item to your cart.
Get an item reminder
We'll email you a link to your item now and follow up with a single reminder (if you'd like one). That's it! No spam, no hassle.
Already have an account?
Log in and add this item to your wish list.